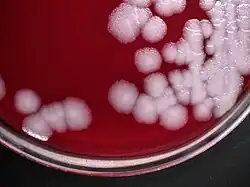

Bacillus anthracis
| Bacillus anthracis | ||||||||||
|---|---|---|---|---|---|---|---|---|---|---|
| ||||||||||
| Научная классификация | ||||||||||
| Международное научное название | ||||||||||
| Bacillus anthracis Cohn 1872 | ||||||||||
| ||||||||||
Bacíllus ánthracis (лат.) (сибиреязвенная палочка[1]) — вид грамположительных спорообразующих бактерий. Возбудитель сибирской язвы. Первый доказанный возбудитель заболеваний человека, выделен в чистую культуру Р. Кохом в 1877 году.
Биологические свойства
Морфология
Неподвижная крупная палочка 1—1,2 × 3—5 мкм, на микропрепаратах располагаются одиночно, попарно в организме или длинными цепочками на питательных средах. Концы клеток бацилл при световой микроскопии кажутся обрубленными или слегка вогнутыми (напоминая бамбуковую трость). Бактериальная клетка образует капсулы. Овальные эндоспоры чаще располагаются центрально[2].
Культуральные свойства
Хемоорганогетеротроф, факультативный анаэроб, растёт на простых питательных средах (в том числе на МПА, МПБ) при 37 °C. Колонии крупные, волокнистые (характерная морфология типа «голова медузы» или «грива льва»[2]), край колонии бахромчатый.
Патогенность
B. anthracis является возбудителем сибирской язвы, отнесён ко II группе патогенности. В факторы патогенности входят:
- Образование капсулы, обладающей антифагоцитарной активностью и адгезивными свойствами;
- Образование термолабильного трёхкомпонентного экзотоксина, состоящего из трёх компонентов — эдематозного компонента (вызывает воспаления, отёки), защитного протективного антигена (не обладает токсичностью) и летального компонента[3][4].
Механизм передачи возбудителя контактный от падшего и больного скота, заражённой спорами бактерии, находящимися в почве.
- Образование спор вне живого организма.
Бактерия Bacillus anthracis может сохраняться в форме спор, никак не проявляя себя, практически до бесконечности — до момента вдыхания, проглатывания или соприкосновения с открытой раной, после чего она активизируется и вызовет смертельно опасную сибирскую язву[5].
Примечания
- ↑ СИБИРСКАЯ ЯЗВА : [арх. 16 июня 2021] // Сен-Жерменский мир 1679 — Социальное обеспечение. — М. : Большая российская энциклопедия, 2015. — С. 131. — (Большая российская энциклопедия : [в 35 т.] / гл. ред. Ю. С. Осипов ; 2004—2017, т. 30). — ISBN 978-5-85270-367-5.
- ↑ 1 2 Архивированная копия. Дата обращения: 2 августа 2008. Архивировано из оригинала 18 июля 2008 года.
- ↑ [https://web.archive.org/web/20181024035633/https://www.ncbi.nlm.nih.gov/pubmed/11595637 Архивная копия от 24 октября 2018 на Wayback Machine {{Wayback&124;url=https://www.ncbi.nlm.nih.gov/pubmed/11595637 &124;date=20181024035633 }} Toxins of Bacillus anthracis. [Toxicon. 2001] — PubMed result]
- ↑ Архивированная копия. Дата обращения: 2 августа 2008. Архивировано 27 июля 2008 года.
- ↑ Остерхолм, 2022, с. 105.
Литература
- Майкл Остерхолм, Марк Олшейкер. Заклятый враг. Наша война со смертельными инфекциями = Deadliest Enemy: Our War Against Killer Germs. — М.: Альпина нон-фикшн , 2022. — 440 с. — ISBN 978-5-00139-564-5..
